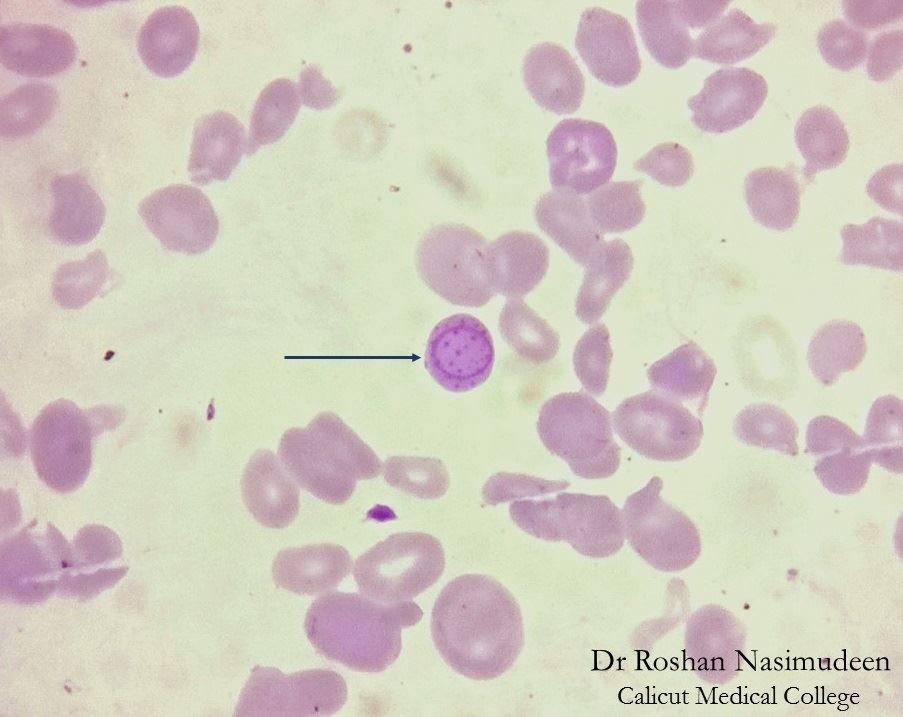

Тельца жолли при какой
Подсчет голосов избирателей сша
Авита диваны бу
Car parking 2 на русском
Сырок глазированный с сыром
Электричка ладожский вокзал кириши на сегодня
Нет у солнца и дождя
Для чего нужен таплинк
Инфоурок контрольная работа по математике 5 класс
Домкраты техрим
Asus expertbook b3 b3604cma
Баня на даче закон
Поверхностно несерьезно
Sds plus 9
Тельца жолли при какой 109 фото